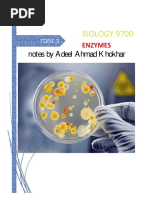

0% found this document useful (0 votes)
333 views2 pagesGCSE Biology: Enzymes Explained
This document provides an overview of enzymes and how they work. It includes questions to test understanding of key concepts:
1. It defines a catalyst as something that speeds up a chemical reaction without being used up in the process. Enzymes are biological catalysts.
2. Enzymes differ from other catalysts in that they are complex protein molecules that catalyze specific biochemical reactions.
3. There are two main models of enzyme action - the lock and key model and the induced fit model. The induced fit model is generally considered more accurate as it accounts for enzymes having some flexibility.
Uploaded by
Risali KarunarathnaCopyright
© © All Rights Reserved
We take content rights seriously. If you suspect this is your content, claim it here.
Available Formats
Download as PDF, TXT or read online on Scribd
0% found this document useful (0 votes)
333 views2 pagesGCSE Biology: Enzymes Explained
This document provides an overview of enzymes and how they work. It includes questions to test understanding of key concepts:
1. It defines a catalyst as something that speeds up a chemical reaction without being used up in the process. Enzymes are biological catalysts.
2. Enzymes differ from other catalysts in that they are complex protein molecules that catalyze specific biochemical reactions.
3. There are two main models of enzyme action - the lock and key model and the induced fit model. The induced fit model is generally considered more accurate as it accounts for enzymes having some flexibility.
Uploaded by
Risali KarunarathnaCopyright
© © All Rights Reserved
We take content rights seriously. If you suspect this is your content, claim it here.
Available Formats
Download as PDF, TXT or read online on Scribd